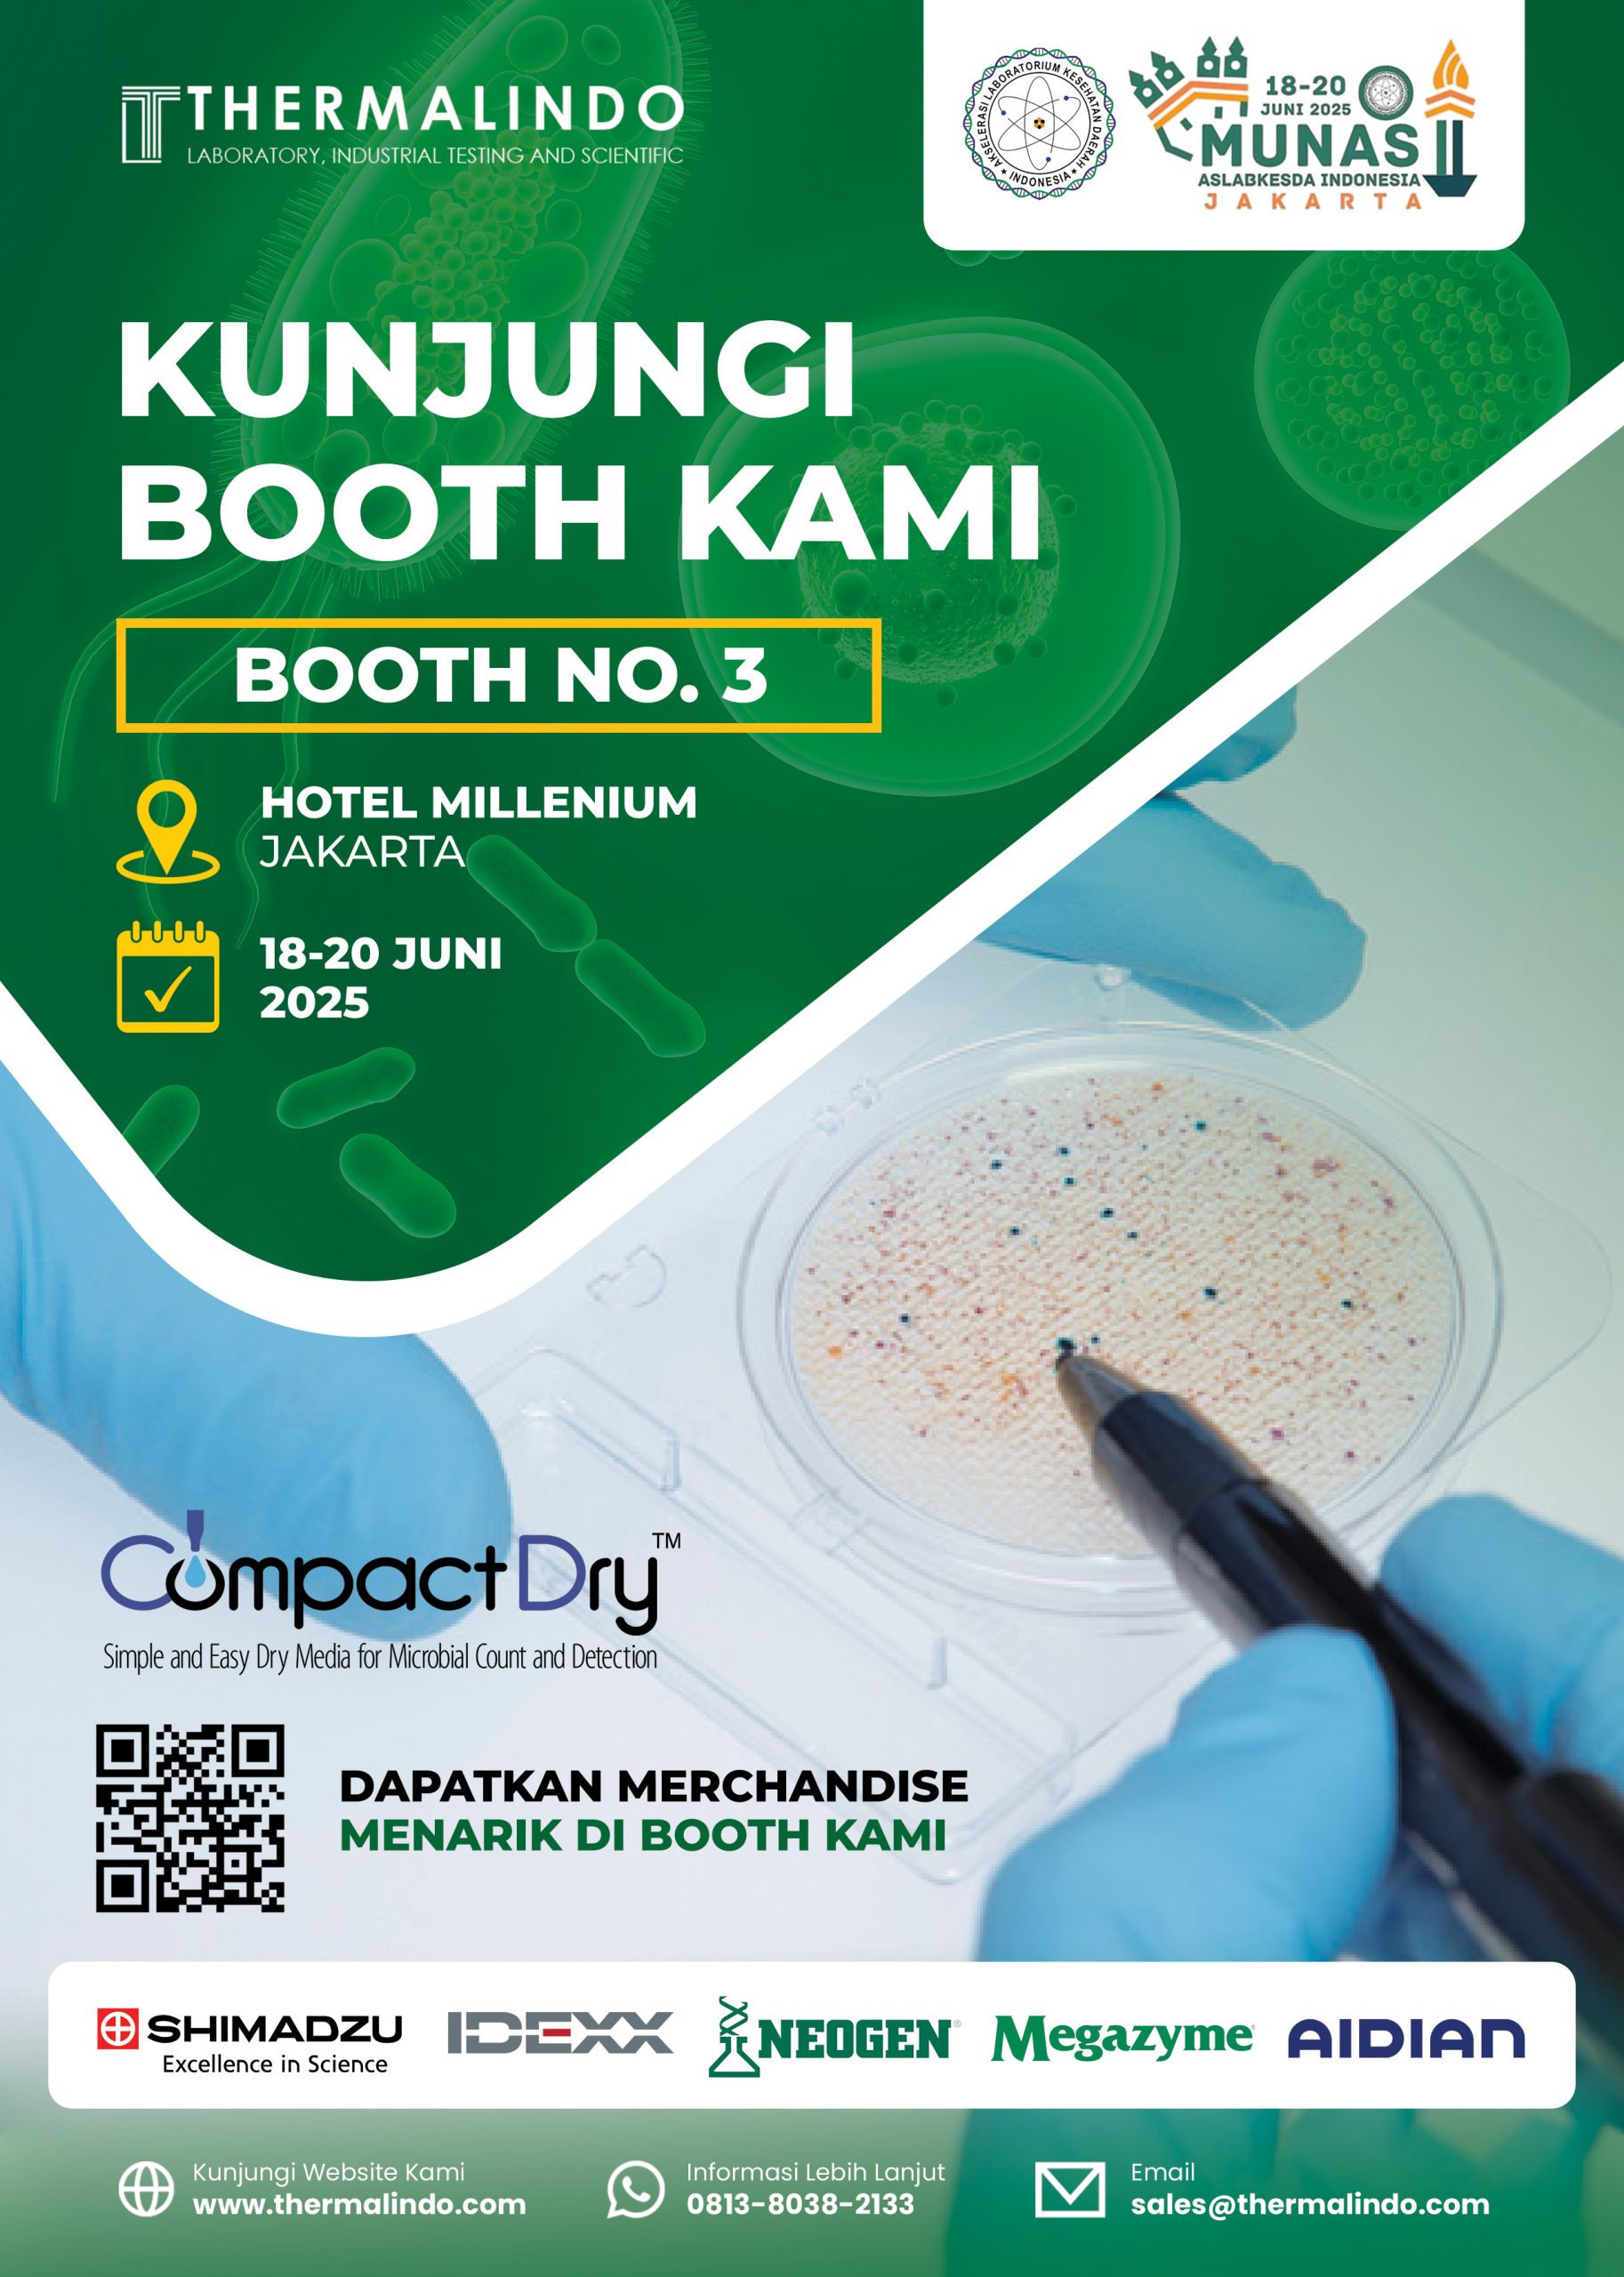

Kepada Yth.
Bapak/Ibu Customer PT. Thermalindo Sarana Laboratoria
Dengan Hormat,
Kami dengan antusias ingin menginformasikan bahwa PT. Thermalindo Sarana Laboratoria akan berpartisipasi dalam MUNAS II dan FORUM ILMIAH IV 2025 ASLABKESDA INDONESIA, yang akan diselenggarakan pada:
đź“… Tanggal: 18-20 Juni 2025
📍 Lokasi: Hotel Millennium, Jakarta
📌 Booth No: 3
Kami mengundang Bapak/Ibu untuk berkunjung ke booth kami, di mana kami akan menampilkan berbagai produk unggulan dan solusi terbaru yang kami hadirkan untuk mendukung kebutuhan Bapak/Ibu di bidang laboratorium.
Selain itu, tersedia merchandise eksklusif bagi pengunjung yang mampir dan berdiskusi langsung bersama tim kami.
Kami percaya, momen ini akan menjadi kesempatan yang baik untuk berbagi informasi, memperkuat hubungan, serta menjajaki potensi kerja sama ke depan.
Jika Bapak/Ibu membutuhkan informasi lebih lanjut, jangan ragu untuk menghubungi kami melalui:
đź“§ [email protected]
📞 0859-6710-4410
Sampai jumpa di MUNAS II dan FORUM ILMIAH IV 2025 ASLABKESDA INDONESIA — kami nantikan kehadiran Bapak/Ibu di booth kami!
Salam hormat,
PT. Thermalindo Sarana Laboratoria






















